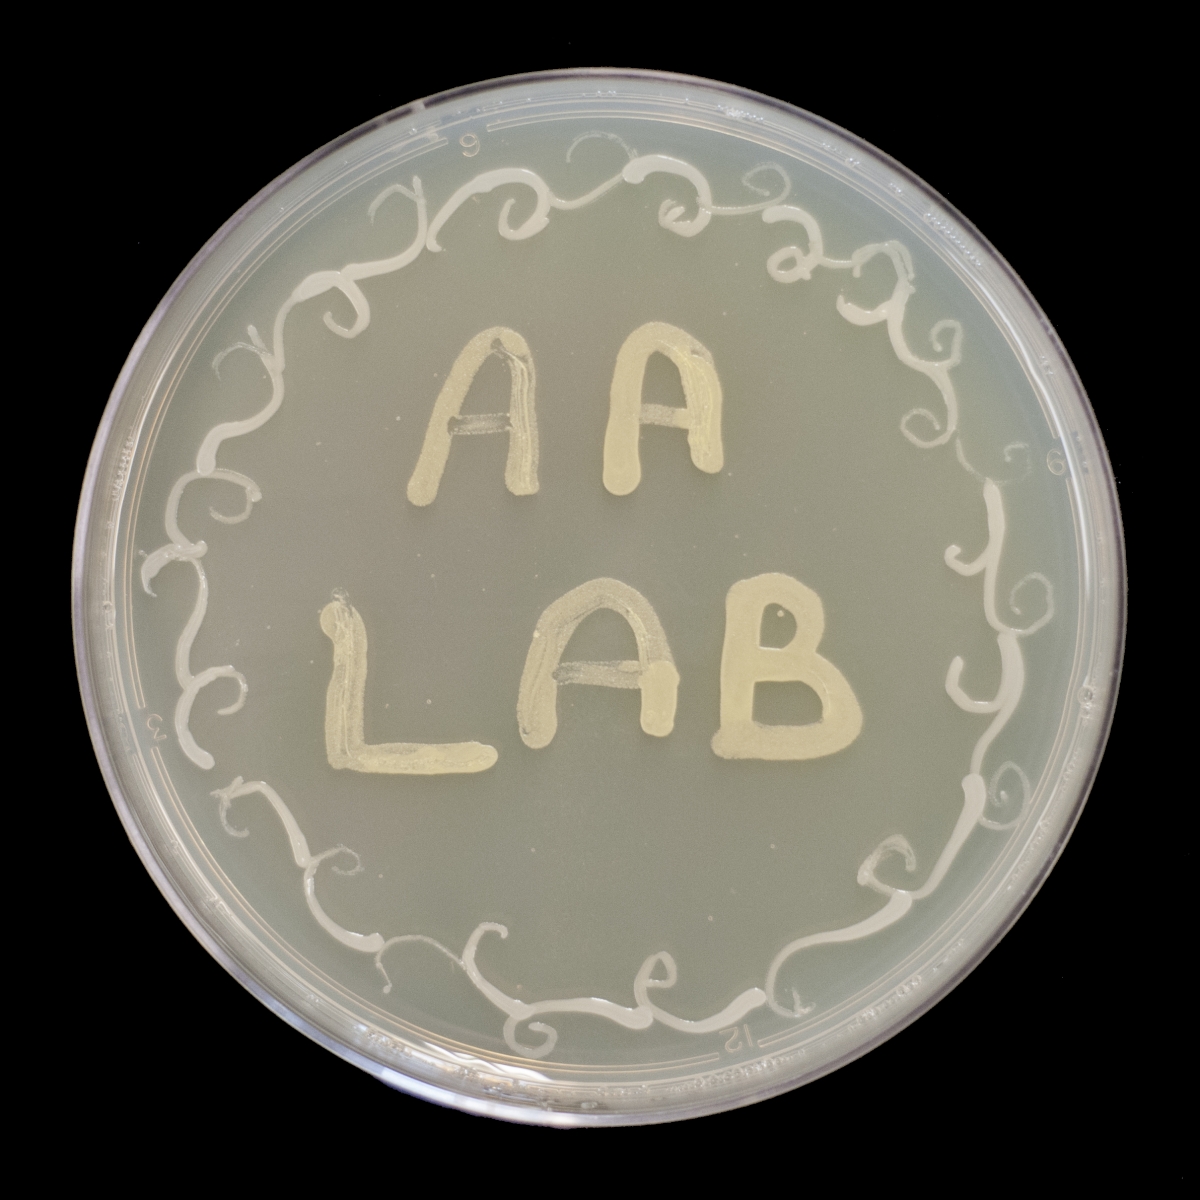

- Prof. Aharoni has been elected to the EMBO Membership. July 9, 2024
- Prof. Asaph Aharoni appointed head of the Department of Plant and Environmental Sciences. December 1, 2020
- Israeli natural food coloring co Phytolon raises 4.1m $ - 16.9.20, Globes
- Prof. Aharoni is the recipient of an American Society of Plant Biology 2020 Award
Available Positions:
- Great opportunity for Postdoc candidates -@AsaphAharoniLab, Weizmann Institute of Science, to work on root signaling and PlantMicrobeInteractions in the rhizosphere.
- The Metabolomics cluster @AsaphAharoniLab is seeking candidates with expertise in mass spectrometry-based metabolite analysis.